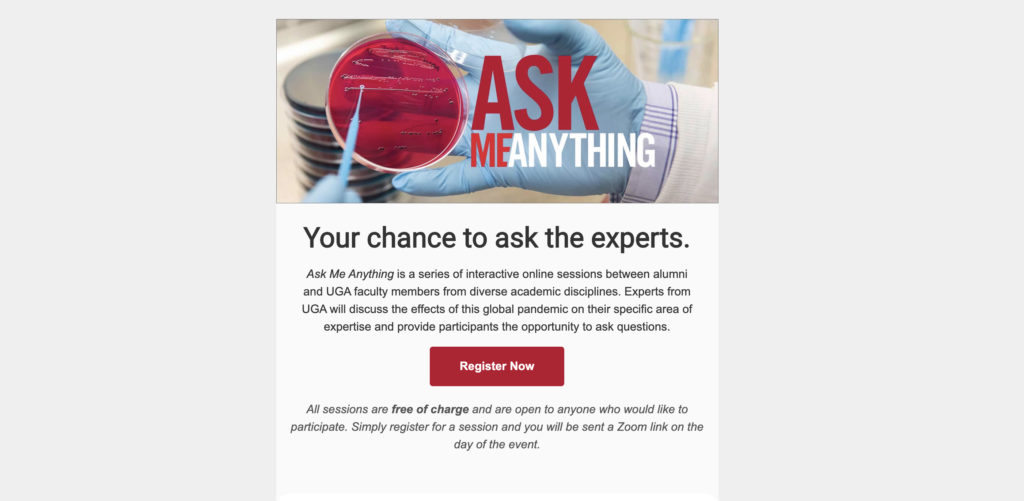
Ask Me Anything interactive online sessions offered

Tag: Division of Development and Alumni Relations
-

Why I Give: Carl Glickman
Name: Carl Glickman Position: Professor Emeritus of Education, former University Professor and past chair of the…
-
November 2020 Foundation funding opportunities
The Foundation Relations team provides UGA faculty and staff with foundation funding opportunities at dar.uga.edu/foundation-relations.…
-

Why I Give: Lynn Bailey
Name: Lynn Bailey Position: Flatt Foods and Nutrition Professor and head of the Department of…
-
October 2020 Foundation funding opportunities
The Foundation Relations team provides UGA faculty and staff with foundation funding opportunities at dar.uga.edu/foundation-relations.…
-

Gifts from alumni create CAES Rural Scholars Program
Scholarship will support rural students in agricultural and environmental sciences.
-

Meaningful relationships define Mentor Program
Since the program’s launch, more than 1,800 relationships have been created.
-

Football coach and wife commit $1 million to UGA
The Smarts’ gift will support social justice, student-athletes impacted by COVID-19.
-

Why I Give: Tina Daly Carpenter
Name: Tina Daly Carpenter Position: Associate professor and EY Faculty Fellow in the J.M. Tull…
-

UGA Foundation allocates additional $500,000 to address pandemic challenges
The discretionary funds will help address ongoing challenges caused by the pandemic.
-

Former UGA football star pledges $1.5 million
Matthew Stafford and wife, Kelly, will support social justice, scholarships.
-

Preparing for a safe return to campus
UGA students talk about what being Dawg Strong means to them.
-
August 2020 Foundation funding opportunities
The Foundation Relations team provides UGA faculty and staff with foundation funding opportunities at dar.uga.edu/foundation-relations.…
-

UGA Foundation commits up to $10 million for innovation
The funds will help bring new technology developed at UGA to the marketplace.
-

Looking back at a historic academic year
We reflect on moments of achievement, hardship during past academic year.
-

Why I Give: Gary Burtle
Name: Gary Burtle Position: Associate professor of animal and dairy science At UGA: 33 years Beneficiary…
-

UGA Foundation elects 12 new trustees
New members will join current trustees on a 50-member board.
-

University of Georgia unveils 40 Under 40 Class of 2020
Alumni Association recognizes outstanding graduates under the age of 40.
-

UGA completes historic fundraising campaign
Campaign raises $1.45 billion, the most successful fundraising in UGA’s history.
-
July 2020 Foundation funding opportunities
The Foundation Relations team provides UGA faculty and staff with foundation funding opportunities at dar.uga.edu/foundation-relations.…
-

Why I Give: Audrey Haynes
Name: Audrey Haynes Position: Josiah Meigs Distinguished Teaching Professor; associate professor of political science; director,…
-
June 2020 Foundation funding opportunities
The Foundation Relations team provides UGA faculty and staff with foundation funding opportunities at dar.uga.edu/foundation-relations.…
-
Ask Me Anything interactive online sessions offered
Ask Me Anything is a series of interactive online sessions between alumni and UGA faculty…
-

Why I Give: Tony Waller
Name: Tony Waller Position: Director of Public Sector Career Advising and Bar Exam Success Programming…

